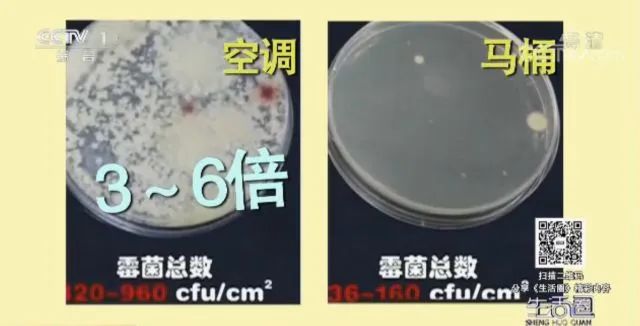
空调使用不当比马桶还脏!这5种家电,正在吞噬你的健康

冰箱、空调、抽油烟机
这些家用电器家家都有
咱们的生活也离不开它们的帮助
但朋友们知道吗
危害咱们健康的隐形杀手
可能就隐藏在这些家用电器中
1
空调使用不当比马桶还脏
错误用法:
长期不清洗的空调比马桶还脏,待在这样的空调环境下,时间长了就会危害健康 。

文章图片
; ; ;
文章图片
; ; ;第一个是传染性疾病;第二是霉菌、常见的慢性疾病;第三是肺炎、哮喘 。

文章图片
; ; ; ;正确用法:
定期对空调进行清洗 。; ; ;
清洗空调的方法:
● 把空调插头拔掉,进行断电;
●;打开空调盖子取下过滤网,用水冲洗掉网上的污垢,用洗碗布或者小刷子效果更好;
●;在抹布上喷洒适量花露水,擦拭散热片,如此一来就可以去除散热片上的污垢了,还可以让吹出来的风更加清凉;
●;最后将晾干的过滤网插回原处,盖好盖子,插上电源,空调就清洗完毕了 。; ; ;
注意:条件允许还是建议定期请专业的清洁人员对空调做彻底清洁 。
2
加湿器使用不当会引起肺部炎症
不注意对加湿器进行清洗 。
加湿器使用不当会造成肺部炎症,分为感染性和非感染性,很多人使用加湿器只会不断往里面加水,很少清理消毒,不做定期清洗就很容易有一些杂质沉淀在其中,并且滋生细菌 。这些细菌又通过加湿器形成的水雾吸入到肺部,引起呼吸道疾病,引起肺炎,这是感染性的 。
对加湿器中的一种物质过敏称为是非感染性的肺炎 。因为加湿器长期使用不清理,中间可能会有一些蛋白质,甚至一些细菌或者细菌的裂解产物,这些有机物雾化吸入到人体之后,可能会引起肺部的一些非特异性炎症反应 。; ;
正确用法:
用加湿器一定要每天定时清理,弄干之后再加水,这样才能预防因为吸入有菌的加湿器湿气引起的肺部炎症 。
特别声明:本站内容均来自网友提供或互联网,仅供参考,请勿用于商业和其他非法用途。如果侵犯了您的权益请与我们联系,我们将在24小时内删除。
